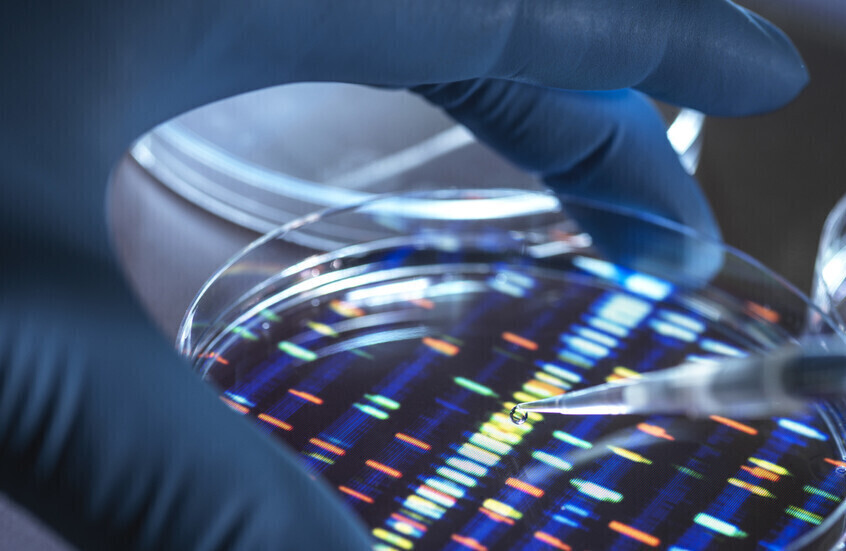
اكتشاف قدرات خفية لدى الميكروبات في المختبر تحدث في البيئة الطبيعية

Stories
-
![مونديال 2026]()
مونديال 2026
RT STORIES
تطور جديد في أزمة إيران.. انفراجة محدودة للمنتخب قبل انطلاق مشواره في المونديال
![تطور جديد في أزمة إيران.. انفراجة محدودة للمنتخب قبل انطلاق مشواره في المونديال]() #اسأل_أكثر #Question_More
#اسأل_أكثر #Question_MoreRT STORIES
مزحة المونديال تتحول إلى أزمة بين فيفا وإيطاليا
![مزحة المونديال تتحول إلى أزمة بين فيفا وإيطاليا]() #اسأل_أكثر #Question_More
#اسأل_أكثر #Question_MoreRT STORIES
اليوم الرابع من مونديال 2026.. تابعوا الحدث لحظة بلحظة!
![اليوم الرابع من مونديال 2026.. تابعوا الحدث لحظة بلحظة!]() #اسأل_أكثر #Question_More
#اسأل_أكثر #Question_MoreRT STORIES
المغرب يفرض تعادلا تاريخيا على البرازيل في كأس العالم 2026
![المغرب يفرض تعادلا تاريخيا على البرازيل في كأس العالم 2026]() #اسأل_أكثر #Question_More
#اسأل_أكثر #Question_MoreRT STORIES
صيباري يهز شباك البرازيل ويخلد اسمه في تاريخ كأس العالم
![صيباري يهز شباك البرازيل ويخلد اسمه في تاريخ كأس العالم]() #اسأل_أكثر #Question_More
#اسأل_أكثر #Question_MoreRT STORIES
لقطة مؤثرة لحارس منتخب قطر بعد فوزه بجائزة أفضل لاعب في مباراة سويسرا
![لقطة مؤثرة لحارس منتخب قطر بعد فوزه بجائزة أفضل لاعب في مباراة سويسرا]() #اسأل_أكثر #Question_More
#اسأل_أكثر #Question_MoreRT STORIES
ترامب يوجه رسالة لمنتخب الولايات المتحدة بعد فوزه العريض على باراغواي
![ترامب يوجه رسالة لمنتخب الولايات المتحدة بعد فوزه العريض على باراغواي]() #اسأل_أكثر #Question_More
#اسأل_أكثر #Question_MoreRT STORIES
عرافة برازيلية: كائنات فضائية ستخطف لاعبين خلال مباراة منتخب البرازيل في مونديال 2026
![عرافة برازيلية: كائنات فضائية ستخطف لاعبين خلال مباراة منتخب البرازيل في مونديال 2026]() #اسأل_أكثر #Question_More
#اسأل_أكثر #Question_MoreRT STORIES
مدرب السنغال يثير الجدل بشأن ممارسة الشعائر الدينية خلال بطولة كأس العالم
![مدرب السنغال يثير الجدل بشأن ممارسة الشعائر الدينية خلال بطولة كأس العالم]() #اسأل_أكثر #Question_More
#اسأل_أكثر #Question_MoreRT STORIES
أول رد رسمي من غانا بعد منع نجم منتخبها بارتي من دخول كندا
![أول رد رسمي من غانا بعد منع نجم منتخبها بارتي من دخول كندا]() #اسأل_أكثر #Question_More
#اسأل_أكثر #Question_MoreRT STORIES
بعد توقعه فوز رونالدو بكأس العالم 2026.. رد فعل مفاجئ تجاه سبيد على الهواء (فيديو)
![بعد توقعه فوز رونالدو بكأس العالم 2026.. رد فعل مفاجئ تجاه سبيد على الهواء (فيديو)]() #اسأل_أكثر #Question_More
#اسأل_أكثر #Question_MoreRT STORIES
منتخب بلجيكا يتخذ قرارا مفاجئا قبل مواجهة مصر في كأس العالم
![منتخب بلجيكا يتخذ قرارا مفاجئا قبل مواجهة مصر في كأس العالم]() #اسأل_أكثر #Question_More
#اسأل_أكثر #Question_MoreRT STORIES
وهبي يكشف آخر تطورات حالة نصير مزراوي قبيل مواجهة البرازيل
![وهبي يكشف آخر تطورات حالة نصير مزراوي قبيل مواجهة البرازيل]() #اسأل_أكثر #Question_More
#اسأل_أكثر #Question_MoreRT STORIES
تعديلان اضطراريان في تشكيلة المغرب لمواجهة البرازيل في مونديال 2026
![تعديلان اضطراريان في تشكيلة المغرب لمواجهة البرازيل في مونديال 2026]() #اسأل_أكثر #Question_More
#اسأل_أكثر #Question_MoreRT STORIES
"تعرضت للسرقة".. صحفية بريطانية تكشف كواليس فوضى كأس العالم (فيديو)
!["تعرضت للسرقة".. صحفية بريطانية تكشف كواليس فوضى كأس العالم (فيديو)]() #اسأل_أكثر #Question_More
#اسأل_أكثر #Question_MoreRT STORIES
أنشيلوتي يؤكد رسميا غياب نيمار عن مواجهة المغرب
![أنشيلوتي يؤكد رسميا غياب نيمار عن مواجهة المغرب]() #اسأل_أكثر #Question_More
#اسأل_أكثر #Question_MoreRT STORIES
قبل مواجهة نيوزيلندا.. العثور على جثة يربك أجواء المنتخب الإيراني
![قبل مواجهة نيوزيلندا.. العثور على جثة يربك أجواء المنتخب الإيراني]() #اسأل_أكثر #Question_More
#اسأل_أكثر #Question_More![مونديال 2026]() مونديال 2026
مونديال 2026
-
![العملية العسكرية الروسية في أوكرانيا]()
العملية العسكرية الروسية في أوكرانيا
RT STORIES
مراسل حربي ينقل من أرض الميدان بطولات اللواء الروسي الرابع في كونستانتينوفكا
![مراسل حربي ينقل من أرض الميدان بطولات اللواء الروسي الرابع في كونستانتينوفكا]() #اسأل_أكثر #Question_More
#اسأل_أكثر #Question_MoreRT STORIES
دوديك: حكمة بوتين منعت شن غارات واسعة النطاق على أوكرانيا مما حفظ أرواح المدنيين
![دوديك: حكمة بوتين منعت شن غارات واسعة النطاق على أوكرانيا مما حفظ أرواح المدنيين]() #اسأل_أكثر #Question_More
#اسأل_أكثر #Question_MoreRT STORIES
NYT: نقص حاد في صواريخ "باتريوت" الاعتراضية يهدد الدفاع الجوي الأوكراني
![NYT: نقص حاد في صواريخ "باتريوت" الاعتراضية يهدد الدفاع الجوي الأوكراني]() #اسأل_أكثر #Question_More
#اسأل_أكثر #Question_MoreRT STORIES
إصابة 7 مدنيين جراء قصف أوكراني استهدف سوق سفاتوفو في لوغانسك الشعبية
![إصابة 7 مدنيين جراء قصف أوكراني استهدف سوق سفاتوفو في لوغانسك الشعبية]() #اسأل_أكثر #Question_More
#اسأل_أكثر #Question_MoreRT STORIES
مقاطعة زابوروجيه.. راجمات الصواريخ "غراد" الروسية تدمر موقعا للقوات المسلحة الأوكرانية
#اسأل_أكثر #Question_MoreRT STORIES
مقاطعة زابوروجيه.. قاذفات صواريخ "غفوزديكا" الروسية تستهدف مواقع الجيش الأوكراني
#اسأل_أكثر #Question_MoreRT STORIES
جمهورية دونيتسك.. خبراء المتفجرات يطهرون الأراضي المحررة من الألغام
#اسأل_أكثر #Question_MoreRT STORIES
انقسام بين أصحاب العمل والنقابات في فنلندا بشأن أجور المتضررين من هجمات المسيرات الأوكرانية
![انقسام بين أصحاب العمل والنقابات في فنلندا بشأن أجور المتضررين من هجمات المسيرات الأوكرانية]() #اسأل_أكثر #Question_More
#اسأل_أكثر #Question_MoreRT STORIES
مسؤول أوكراني سابق يحذر من انتفاضة محتملة ضد زيلينسكي في كييف
![مسؤول أوكراني سابق يحذر من انتفاضة محتملة ضد زيلينسكي في كييف]() #اسأل_أكثر #Question_More
#اسأل_أكثر #Question_MoreRT STORIES
مقتل شخص وإصابة ثلاثة آخرين جراء هجوم مسيرة أوكرانية في إقليم كراسنودار الروسي
![مقتل شخص وإصابة ثلاثة آخرين جراء هجوم مسيرة أوكرانية في إقليم كراسنودار الروسي]() #اسأل_أكثر #Question_More
#اسأل_أكثر #Question_More![العملية العسكرية الروسية في أوكرانيا]() العملية العسكرية الروسية في أوكرانيا
العملية العسكرية الروسية في أوكرانيا
-
![اتفاق وقف إطلاق النار بين إسرائيل ولبنان]()
اتفاق وقف إطلاق النار بين إسرائيل ولبنان
RT STORIES
تقرير عبري عن شكل انسحاب الجيش الإسرائيلي من جنوب لبنان وشروط إسرائيل
![تقرير عبري عن شكل انسحاب الجيش الإسرائيلي من جنوب لبنان وشروط إسرائيل]() #اسأل_أكثر #Question_More
#اسأل_أكثر #Question_MoreRT STORIES
الصحة اللبنانية: ارتفاع حصيلة ضحايا الهجمات الإسرائيلية إلى 3,756 قتيلا و11,632 مصابا
![الصحة اللبنانية: ارتفاع حصيلة ضحايا الهجمات الإسرائيلية إلى 3,756 قتيلا و11,632 مصابا]() #اسأل_أكثر #Question_More
#اسأل_أكثر #Question_MoreRT STORIES
الجيش الإسرائيلي يعلن القضاء على 7 عناصر من حزب الله في جنوب لبنان (فيديو)
![الجيش الإسرائيلي يعلن القضاء على 7 عناصر من حزب الله في جنوب لبنان (فيديو)]() #اسأل_أكثر #Question_More
#اسأل_أكثر #Question_MoreRT STORIES
وزير خارجية لبنان: نزع سلاح حزب الله للعيش في بلد طبيعي وليس لإرضاء أمريكا أو إسرائيل
![وزير خارجية لبنان: نزع سلاح حزب الله للعيش في بلد طبيعي وليس لإرضاء أمريكا أو إسرائيل]() #اسأل_أكثر #Question_More
#اسأل_أكثر #Question_MoreRT STORIES
"حزب الله": على السلطة اللبنانية تصحيح أخطائها والإقلاع عن سياسة الانسحاق أمام الإسرائيلي
!["حزب الله": على السلطة اللبنانية تصحيح أخطائها والإقلاع عن سياسة الانسحاق أمام الإسرائيلي]() #اسأل_أكثر #Question_More
#اسأل_أكثر #Question_MoreRT STORIES
سلام يخاطب "حزب الله" بضرورة تغليب مصلحة لبنان والالتزام بالتعهدات لتأمين انسحاب إسرائيل
![سلام يخاطب "حزب الله" بضرورة تغليب مصلحة لبنان والالتزام بالتعهدات لتأمين انسحاب إسرائيل]() #اسأل_أكثر #Question_More
#اسأل_أكثر #Question_MoreRT STORIES
عون: لبنان يقف اليوم أمام استحقاق مصيري
![عون: لبنان يقف اليوم أمام استحقاق مصيري]() #اسأل_أكثر #Question_More
#اسأل_أكثر #Question_More![اتفاق وقف إطلاق النار بين إسرائيل ولبنان]() اتفاق وقف إطلاق النار بين إسرائيل ولبنان
اتفاق وقف إطلاق النار بين إسرائيل ولبنان
-
![المواجهة الأمريكية الإسرائيلية مع إيران بين المد والجزر]()
المواجهة الأمريكية الإسرائيلية مع إيران بين المد والجزر
RT STORIES
إيران توضح اللغط حول تسمية "الاتفاق" المرتقب توقيعه بين طهران وواشنطن
![إيران توضح اللغط حول تسمية "الاتفاق" المرتقب توقيعه بين طهران وواشنطن]() #اسأل_أكثر #Question_More
#اسأل_أكثر #Question_MoreRT STORIES
رئيس الوزراء الباكستاني: من المرجح إتمام اتفاق السلام بين واشنطن وطهران خلال الـ24 ساعة المقبلة
![رئيس الوزراء الباكستاني: من المرجح إتمام اتفاق السلام بين واشنطن وطهران خلال الـ24 ساعة المقبلة]() #اسأل_أكثر #Question_More
#اسأل_أكثر #Question_MoreRT STORIES
البرلمان الإيراني يعلن عن 3 خطوط حمراء تتطلب مراجعته في أي اتفاق محتمل مع أمريكا
![البرلمان الإيراني يعلن عن 3 خطوط حمراء تتطلب مراجعته في أي اتفاق محتمل مع أمريكا]() #اسأل_أكثر #Question_More
#اسأل_أكثر #Question_MoreRT STORIES
"سي إن إن" تكشف تحركات إيرانية بشأن اليورانيوم تحسبا لعملية أمريكية
!["سي إن إن" تكشف تحركات إيرانية بشأن اليورانيوم تحسبا لعملية أمريكية]() #اسأل_أكثر #Question_More
#اسأل_أكثر #Question_MoreRT STORIES
إسرائيل و"اتفاق أمريكي إيراني يشمل لبنان".. السيناريوهات المحتملة
![إسرائيل و"اتفاق أمريكي إيراني يشمل لبنان".. السيناريوهات المحتملة]() #اسأل_أكثر #Question_More
#اسأل_أكثر #Question_MoreRT STORIES
ترامب يفتح "الدفاتر القديمة" وعراقجي يتصدر منصة "تروث سوشال" وسط أنباء عن اتفاق
![ترامب يفتح "الدفاتر القديمة" وعراقجي يتصدر منصة "تروث سوشال" وسط أنباء عن اتفاق]() #اسأل_أكثر #Question_More
#اسأل_أكثر #Question_More![المواجهة الأمريكية الإسرائيلية مع إيران بين المد والجزر]() المواجهة الأمريكية الإسرائيلية مع إيران بين المد والجزر
المواجهة الأمريكية الإسرائيلية مع إيران بين المد والجزر
-
فيديوهات
RT STORIES
انسحاب الجيش اللبناني من بلدة كفرتبنيت بعد توغل القوات الإسرائيلية
#اسأل_أكثر #Question_MoreRT STORIES
الهند.. تحطم طائرة نقل عسكرية من طراز "أن-32"
#اسأل_أكثر #Question_MoreRT STORIES
وسائل الإعلام الأمريكية تعلن عن مقتل زعيم المنظمة الإجرامية الفنزويلية "ترين دي أراغوا"
#اسأل_أكثر #Question_Moreفيديوهات
-
![الأهلي يعين أول مدرب عربي غير مصري في تاريخه]()
الأهلي يعين أول مدرب عربي غير مصري في تاريخه
RT STORIES
الأهلي يعين أول مدرب عربي غير مصري في تاريخه
![الأهلي يعين أول مدرب عربي غير مصري في تاريخه]() #اسأل_أكثر #Question_More
#اسأل_أكثر #Question_More -
![في الوقت القاتل.. قطر تخطف النقطة الأولى لها في تاريخها بالمونديال أمام سويسرا]()
في الوقت القاتل.. قطر تخطف النقطة الأولى لها في تاريخها بالمونديال أمام سويسرا
RT STORIES
في الوقت القاتل.. قطر تخطف النقطة الأولى لها في تاريخها بالمونديال أمام سويسرا
![في الوقت القاتل.. قطر تخطف النقطة الأولى لها في تاريخها بالمونديال أمام سويسرا]() #اسأل_أكثر #Question_More
#اسأل_أكثر #Question_More
أين تنتشر البكتيريا الفائقة؟
يوضح الدكتور ميخائيل فولكوف كبير الباحثين في معهد علم المناعة وعلم وظائف الأعضاء، أماكن انتشار البكتيريا الفائقة المقاومة لمضادات الحيوية.


مقاومة لمضادات الحيوية.. علماء يحذرون من البكتيريا الفائقة!
ويشير الخبير إلى أن مجلة The Lancet الطبية أفادت أن خبراء منظمة الصحة العالمية وكبار أطباء العالم توصلوا إلى استنتاج مفاده أن هذه البكتيريا سوف تقضي على حياة 39 مليون شخص بحلول عام 2050.
ويقول: "البكتيريا الفائقة مقاومة لمختلف مضادات الحيوية. وكقاعدة تعيش هذه البكتيريا في المستشفيات. أي أن انتشارها في الوسط المحيط سيء لأن مقاومة مضادات الحيوية غالبا ما تتطور نتيجة تخلي البكتيريا عن بعض الأغشية التي تستهدفها مضادات الحيوية. واتضح أنه ليس في المستشفيات أي منافس لها".
ووفقا له، من الصعب مكافحة بكتيريا، مثل المكورات العنقودية الذهبية المقاومة للميثيسيلين وسلالات الإشريكة Escherichia coli. مشيرا إلى أن البكتيريا الفائقة تنتشر في وحدات العناية المركزة بصورة خاصة. وهذا ما تعاني منه مثلا مستشفيات فرنسا والولايات المتحدة، حيث أصبحت هذه مشكلة حادة هناك.
ويشير الخبير، إلى أنه سوف تنفق أموال هائلة في مكافحة هذه البكتيريا، لأنها سوف تهيمين من حيث خطورتها، لذلك يعمل الخبراء في مختلف دول العالم على ابتكار أنواع جديدة من مضادات الحيوية وأدوية مماثلة لها، التي ستساعد في القضاء عليها بطريقة مغايرة عن مضادات الحيوية التقليدية.
ويؤكد فولكوف، يكلف ابتكار دواء واحد من هذا النوع الدولة وشركات الأدوية مبالغ طائلة، لذلك من الصعب مواكبة تطور مقاومة البكتيريا لمضادات الحيوية.
المصدر: صحيفة "إزفيستيا"
إقرأ المزيد

مضاد حيوي شائع قد يحدث تحولا في علاج حمى التيفوئيد
اكتشف فريق من الباحثين من جامعة كورنيل فعالية المضاد الحيوي "ريفامبين" بنسبة 99.9% ضد بكتيريا السالمونيلا التيفية، المسببة لحمى التيفوئيد.

خبير يدق ناقوس الخطر بشأن بكتيريا خطيرة
أعلن غريغوري وينتر، الأستاذ بجامعة كامبريدج والحائز على جائزة نوبل في الكيمياء، أن مواجهة ما يسمى بالميكروبات المرآة قد تكون مستحيلة إذا غادرت المختبرات.

اكتشاف صخرة عمرها 2 مليار عام تحتوي على ميكروبات حية!
اكتشفت مجموعة دولية من العلماء كائنات دقيقة حية داخل شق في صخرة عمرها ملياري عام، تمثل أقدم دليل معروف على الحياة الميكروبية، حسبما أفادت جامعة طوكيو.
اكتشاف قدرات خفية لدى الميكروبات في المختبر تحدث في البيئة الطبيعية
أظهرت دراسة جديدة أن البكتيريا يمكن أن تطور حساسية جديدة متزايدة لمستويات الحمض عند تعرضها لتطرفات بيئية مختلفة في المختبر.
























































































































































التعليقات